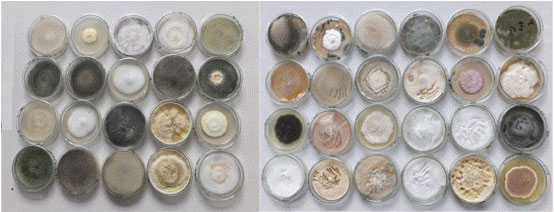

|
|
|
|
廠(chǎng)房(fáng)外景 |
生(shēng)産一區 |
|
|
|
|
生(shēng)産車間 |
菌種保藏室 |

|
我們擁有全國(guó)最大(dà)的PGPR菌種資源庫,保存着36種不同功能的PGPR菌種和20多種其它有益菌。這也是我們的産品質量、效果能得(de)到保證的根本。
|
|

《北方地區主要作(zuò)物病原菌庫》保存着100多種常見(jiàn)病原菌。 這些病原菌是基礎研究和産品開發的有力工(gōng)具。